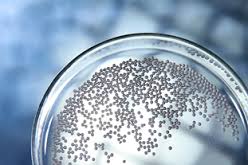
Що таке технічна кераміка: детальний розбір та приклади

Зміст:
- 1 Основні фази
- 2 Різновиди
- 2.1 Застосування
- 2.2 Виробництво
- 2.3 Наші рекомендації:
Технічна кераміка – це штучним чином синтезовані матеріали з різним фазовим і хімічним складом.

Фото моделей технічної кераміки
Саме тому вона має ряд специфічних властивостей. Вона або містить глину в малих дозах, або глина в її складі взагалі відсутня. Головними елементами даної різновиду кераміки є оксиди та сполуки металів(безкисневі). Багато її види мають спечену структуру і поликристаллическое будова. При виробництві використовуються спеціальні технологічні прийоми.
Основні фази
Воно з технічних станів кераміки
Технічний стан складається з 3 фаз:
Різновиди

Технологічний процес виготовлення
На сьогоднішній день, виділяють 3 основних різновиди даної кераміки, які мають унікальні властивості:
Застосування
Технічна кераміка використовується майже у всіх сферах життя. Це обумовлено тим, що вона володіє рядом універсальних властивостей:
- стійка до перепадів температур
- не містить домішок
- високі антикорозійні властивості
- здатна витримувати вплив магнітного поля
- стійка до атмосферних впливів і ультрафіолету
- стійка до впливу електроенергії
- володіє хімічною стійкістю
- стійка до всякого роду механічних пошкоджень

Ще одне фото предметів із технічної кераміки
Вироби з технічної кераміки знаходять широке застосування в багатьох галузях промисловості:
- в медичній сфері, застосовується при виробництві устаткування для ультразвукового очищення. У стоматології при виготовленні протезів;
- в електроніці (ізоляційні труби для вакуумних установок, різна техніка для зондування, фотоелектричне дослідницьке обладнання тощо);
- у авіаційної, космічної промисловості;
- в автомобілебудуванні (підшипники кочення і ковзання, направляючі, поршні дозувальних насосів тощо);
- в приладобудуванні;
- у побутовій сфері (вогнетриви та технічна кераміка для інших побутових потреб тощо);
- у сфері будівництва;
- у хімічній промисловості та різних інших областях).
Виробництво

Цех по виробництву технічної кераміки
При виробництві технічної кераміки використовуються специфічні технології.
На даний момент, заводи технічної кераміки пропонують величезний вибір цієї продукції, як стандартної, так і виготовленої з конкретним замовлення для певних робіт і проектів. Купити технічну кераміку можна в спеціалізованих магазинах. Ринок даної продукції досить різноманітний, а високий рівень конкуренції гарантує споживачам широкий вибір продукції.
Ще по темі:
- Вібропресована тротуарна плитка: переваги.
